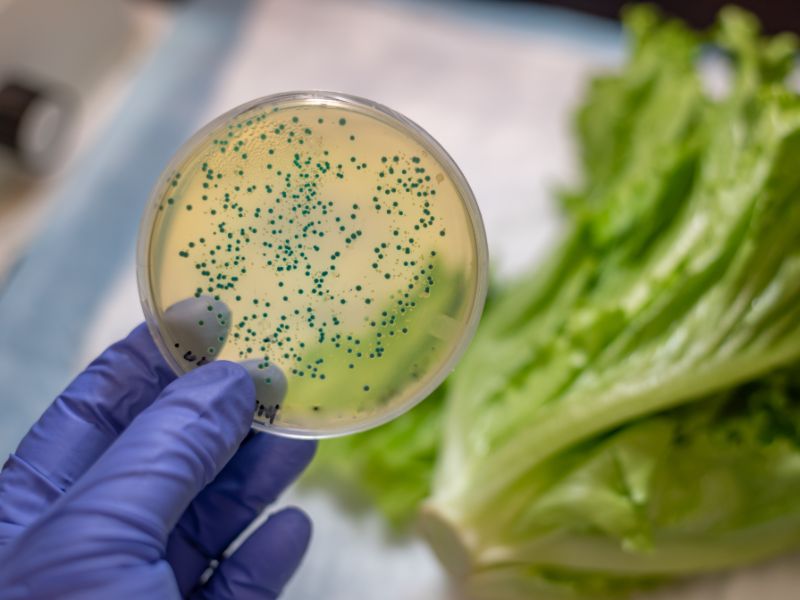

Comprendre et prévenir les TIAC avec la méthode HACCP
Les TIAC, ou Toxi-Infections Alimentaires Collectives, représentent un danger constant dans tout établissement manipulant des denrées alimentaires.
Chez Alvea Formation, nous formons chaque semaine des professionnels sur ces risques, en insistant sur l’application de la méthode HACCP et la prévention des risques alimentaires.
A travers cet article, nous verrons ensemble comment une TIAC se développe et quelles solutions vous pouvez adopter pour maîtriser ce risque au quotidien.
Qu’est-ce qu’une TIAC ?
Une TIAC, c’est lorsqu’au moins deux personnes souffrent de symptômes digestifs similaires après avoir consommé le même aliment contaminé.
Ces événements sont surveillés de près par les autorités sanitaires en raison du potentiel impact sur la santé publique. Ainsi, la déclaration d’une TIAC fait aussitôt l’objet d’enquête et de mesures correctives renforcées, particulièrement lorsqu’elle intervient en restauration collective.
En ce qui concerne les TIAC, la méthode HACCP a pour but de limiter la survenue des intoxications.
Celle-ci permet une prise de conscience sur les enjeux liés aux agents pathogènes et la compréhension de leur mode de transmission. En respectant les préceptes HACCP, on renforce la sécurité tout au long de la chaîne alimentaire.
Quelles bactéries sont responsables des TIAC ?
Plusieurs agents pathogènes sont impliqués dans les TIAC. Les plus connus sont les suivants :
- Salmonella ;
- Escherichia coli ;
- Staphylococcus aureus ;
- Listeria monocytogenes.
Mais ce ne sont pas les seuls ! D’autres micro-organismes comme Bacillus cereus ou Clostridium perfringens peuvent également provoquer des épisodes d’intoxication.
Ces bactéries se développent dans des conditions favorables, notamment lors de ruptures de la chaîne du froid ou du non-respect de certaines procédures d’hygiène alimentaire basiques.
Comment un aliment peut être contaminé ?
Un aliment se retrouve généralement contaminé dès l’origine (par exemple du fait de matières premières contaminées) ou pendant une des étapes de fabrication.
Cette contamination survient par contact direct avec une surface souillée, par le biais de personnel porteur d’agents pathogènes ou via de mauvaises pratiques d’hygiène alimentaire durant la transformation.
En effet, la majorité des TIAC découle d’un manquement ponctuel dans l’application des mesures de contrôle : rupture de température, erreur de cuisson, croisement entre aliments crus et cuits ou lavage incomplet des mains figurent parmi les causes récurrentes observées dans notre pratique.
Lors de nos formations HACCP, nous apprenons à nos élèves repérer les points critiques pouvant favoriser la multiplication des agents pathogènes.
Cela recouvre autant la réception des matières premières contaminées que les erreurs en stockage, les procédures de préparation ou encore le service des plats.
Grâce à des analyses microbiologiques régulières, on peut plus facilement cibler le microorganisme responsable et de comprendre quelle étape de la chaîne alimentaire a failli.
Quels sont les symptômes d’une TIAC ?
- Nausées ;
- Vomissements ;
- Douleurs abdominales ;
- Diarrhée ;
- Maux de tête ;
- Fièvre ;
- Fatigue
Leur intensité varie suivant l’agent pathogène en cause et la quantité d’aliment ingéré. Généralement, ces symptômes apparaissent rapidement, entre quelques heures et 48 heures après l’ingestion.
Attention : parfois, d’autres signes plus graves apparaissent, comme la déshydratation sévère ou des complications neurologiques. L’apparition de tels symptômes exige une prise en charge médicale urgente. Il faut donc toujours prendre très au sérieux toute suspicion de TIAC, même lorsque les premiers signes semblent modérés.
Chez les enfants, personnes âgées ou immunodéprimées, ces troubles peuvent durer plus longtemps ou s’aggraver.
Néanmoins, dans la plupart des cas, les symptômes de TIAC disparaissent en moins de trois jours, surtout si l’organisme est robuste et bien hydraté.
Quoi qu’il en soit, nous recommandons de consulter un professionnel de santé pour éviter toute complication.
Quelles procédures mettre en œuvre en cas de TIAC en restauration ?
Face à une suspicion de toxi-infection alimentaire collective, vous avez 2 choses à faire
- Retirer tous les aliments suspectés et conserver des échantillons pour analyse en laboratoire ;
- Contacter les autorités compétentes et suivre leurs consignes. Cela inclut souvent la fermeture temporaire de l’établissement concerné le temps des investigations.
Nos formations à la méthode HACCP vous expliquent comment réaliser un audit rapide des pratiques internes, interroger le personnel et vérifier l’état des installations.
Ces retours d’expérience servent ensuite de base pour ajuster les mesures de contrôle existantes, renforcer les procédures de nettoyage ou modifier l’organisation en cuisine si besoin.
Comment éviter les TIAC ?
Certains gestes doivent devenir des automatismes pour tout professionnel en contact avec les aliments.
Voici une liste des mesures essentielles à appliquer pour éviter les TIAC :
- Contrôler systématiquement les matières premières à la livraison ;
- Appliquer le principe de marche en avant en cuisine ;
- Vérifier les températures de cuisson, de refroidissement et de conservation des différents aliments ;
- Former régulièrement le personnel aux bonnes pratiques d’hygiène alimentaire ;
- Assurer la propreté constante des locaux et équipements ;
- Tenir à jour la traçabilité et archiver chaque contrôle réalisé.
Au cours de nos formations, nous développons chacun de ces points grâce à des études de cas réels et des ateliers pratiques.
Chacune de ces étapes fait partie intégrante du plan de maîtrise sanitaire obligatoire en restauration commerciale et collective.
FAQ – Les TIAC
Combien de temps un agent pathogène peut survivre sur des surfaces ?
Cela dépend du type de micro-organisme et des conditions environnantes.
Certaines bactéries comme E. coli ou Salmonella peuvent survivre plusieurs heures à plusieurs jours sur des surfaces inertes, tandis que certains virus résistent jusqu’à plusieurs semaines.
D’où l’importance d’un nettoyage et d’une désinfection réguliers des plans de travail et équipements !
Porter des gants aide-t-il à éviter les TIAC ?
Les gants constituent une barrière physique utile, mais ils ne remplacent jamais un lavage des mains rigoureux.
Mal utilisés (changés trop rarement, portés trop longtemps), ils deviennent eux-mêmes vecteurs de contamination. Comme on le dit souvent : mieux vaut des mains propres que des gants sales, en cuisine !
Les produits de désinfection sont-ils assez efficaces pour prévenir les TIAC ?
Oui, à condition de choisir des produits adaptés aux normes alimentaires et de respecter les instructions d’utilisation(concentration, temps de contact).
La désinfection n’est cependant efficace qu’après un nettoyage préalable pour éliminer les résidus organiques.
C’est la combinaison nettoyage + désinfection qui garantit une réduction significative des risques de contamination.
